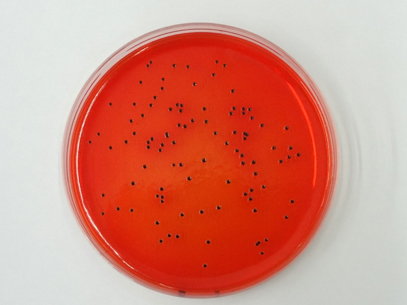
Colonia 3

Sala de prensa
Resultados de la búsqueda
Mostrando coincidencias con:
-
Termociclador para Real -Time PCR
21 oct 2011
La PCR en tiempo real permitr una cuantificación absoluta o relativa de los niveles de ácidos nucleicos de una determinada muestra.

-

-
Secuenciador de ADN
21 oct 2011
La secuenciación automática de ADN utiliza la metodología de Sanger con una polimerasa termostable que permite una reacción de secuenciación cíclica.

-
Chip station
21 oct 2011
El LabChip utiliza la electroforesis capilar para separar los ácidos nucleicos y determinar su nivel de integridad y la cantidad.

-
Morfología colonial
21 oct 2011
Detalle de la morfología colonial de Salmonella en medio selectivo agar XLD (Xilosa-Lisina-Deoxicolat).
-

-

-
Servicio de reproducción equina
21 oct 2011
Aplicación de nuevas tecnologías en la reproducción equina.

-
Escáner de microarrays
21 oct 2011
La lectura de microarrays se lleva a cabo mediante un escáner dotado de dos lásers, y un software específico para la captación de datos (Scan Array).
